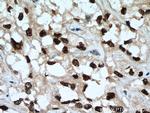
HNF1B Antibody in Immunohistochemistry (Paraffin) (IHC (P))

Search
Proteintech
HNF1B Polyclonal Antibody
{{$productOrderCtrl.translations['antibody.pdp.commerceCard.promotion.promotions']}}
{{$productOrderCtrl.translations['antibody.pdp.commerceCard.promotion.viewpromo']}}
{{$productOrderCtrl.translations['antibody.pdp.commerceCard.promotion.promocode']}}: {{promo.promoCode}} {{promo.promoTitle}} {{promo.promoDescription}}. {{$productOrderCtrl.translations['antibody.pdp.commerceCard.promotion.learnmore']}}
产品信息
12533-1-AP
种属反应
已发表种属
宿主/亚型
分类
类型
抗原
偶联物
形式
浓度
规格
纯化类型
保存液
内含物
保存条件
运输条件
产品详细信息
This is a rabbit polyclonal antibody raised against the N-terminal region of human HNF1B. HNF1B exists some isoforms with MW of 61 kDa, 58 kDa, 46 kDa, and 44 kDa.
Immunogen sequence: MVSKLTSLQ QELLSALLSS GVTKEVLVQA LEELLPSPNF GVKLETLPLS PGSGAEPDTK PVFHTLTNGH AKGRLSGDEG SEDGDDYDTP PILKELQALN TEEAAEQRAE VDRMLSEDPW RAAKMIKGYM QQHNIPQREV VDVTGLNQSH LSQHLNKGTP MKTQKRAALY TWYVRKQREI LRQFNQTVQS SGNMTDKSSQ DQLLFLFPEF SQQSHGPGQS DDACSEPTNK KMRRNRFKWG PASQQILYQA YDRQKNPSKE EREALVEECN RAECLQRGVS PSKAHGLGSN LVTEVRVYNW FANRRKEEAF R (1-310 aa encoded by BC017714)
靶标信息
Hepatocyte Nuclear Factor 1 (HNF1, Homeoprotein LFB3, Transcription factor 2, TCF2, Variant hepatic nuclear factor) is a member of the homeodomain-containing superfamily of transcription factors. It is a liver-specific factor of the homeobox-containing basic helix-turn-helix family. The protein binds to DNA as either a homodimer, or a heterodimer with the related protein hepatocyte nuclear factor 1-alpha. HNF1has been shown to function in nephron development and regulates development of the embryonic pancreas. Mutations in the gene result in renal cysts and diabetes syndrome and noninsulin-dependent diabetes mellitus, and expression of the gene is altered in some types of cancer. Multiple transcript variants encoding different isoforms have been found for this gene.
仅用于科研。不用于诊断过程。未经明确授权不得转售。
生物信息学
蛋白别名: Hepatocyte nuclear factor 1-beta; hepatocyte nuclear factor-1 beta; HNF-1-beta; HNF-1B; HNF1 beta A; Homeoprotein LFB3; TCF-2; TCF2; transcription factor; Transcription factor 2; Transcription factor 2 hepatic; Transcription factor 2 hepatic; LF-B3; variant hepatic nuclear factor; Transcription factor 2, hepatic; Transcription factor 2, hepatic; LF-B3; variant hepatic nuclear factor; unnamed protein product; Variant hepatic nuclear factor 1; vHNF1
基因别名: ADTKD3; FJHN; HNF-1-beta; HNF-1B; HNF-1Beta; HNF1B; HNF1beta; HNF2; HPC11; LF-B3; LFB3; MODY5; RCAD; T2D; TCF-2; TCF2; VHNF1
UniProt ID: (Human) P35680, (Rat) P23899, (Mouse) P27889
Entrez Gene ID: (Human) 6928, (Rat) 25640, (Mouse) 21410